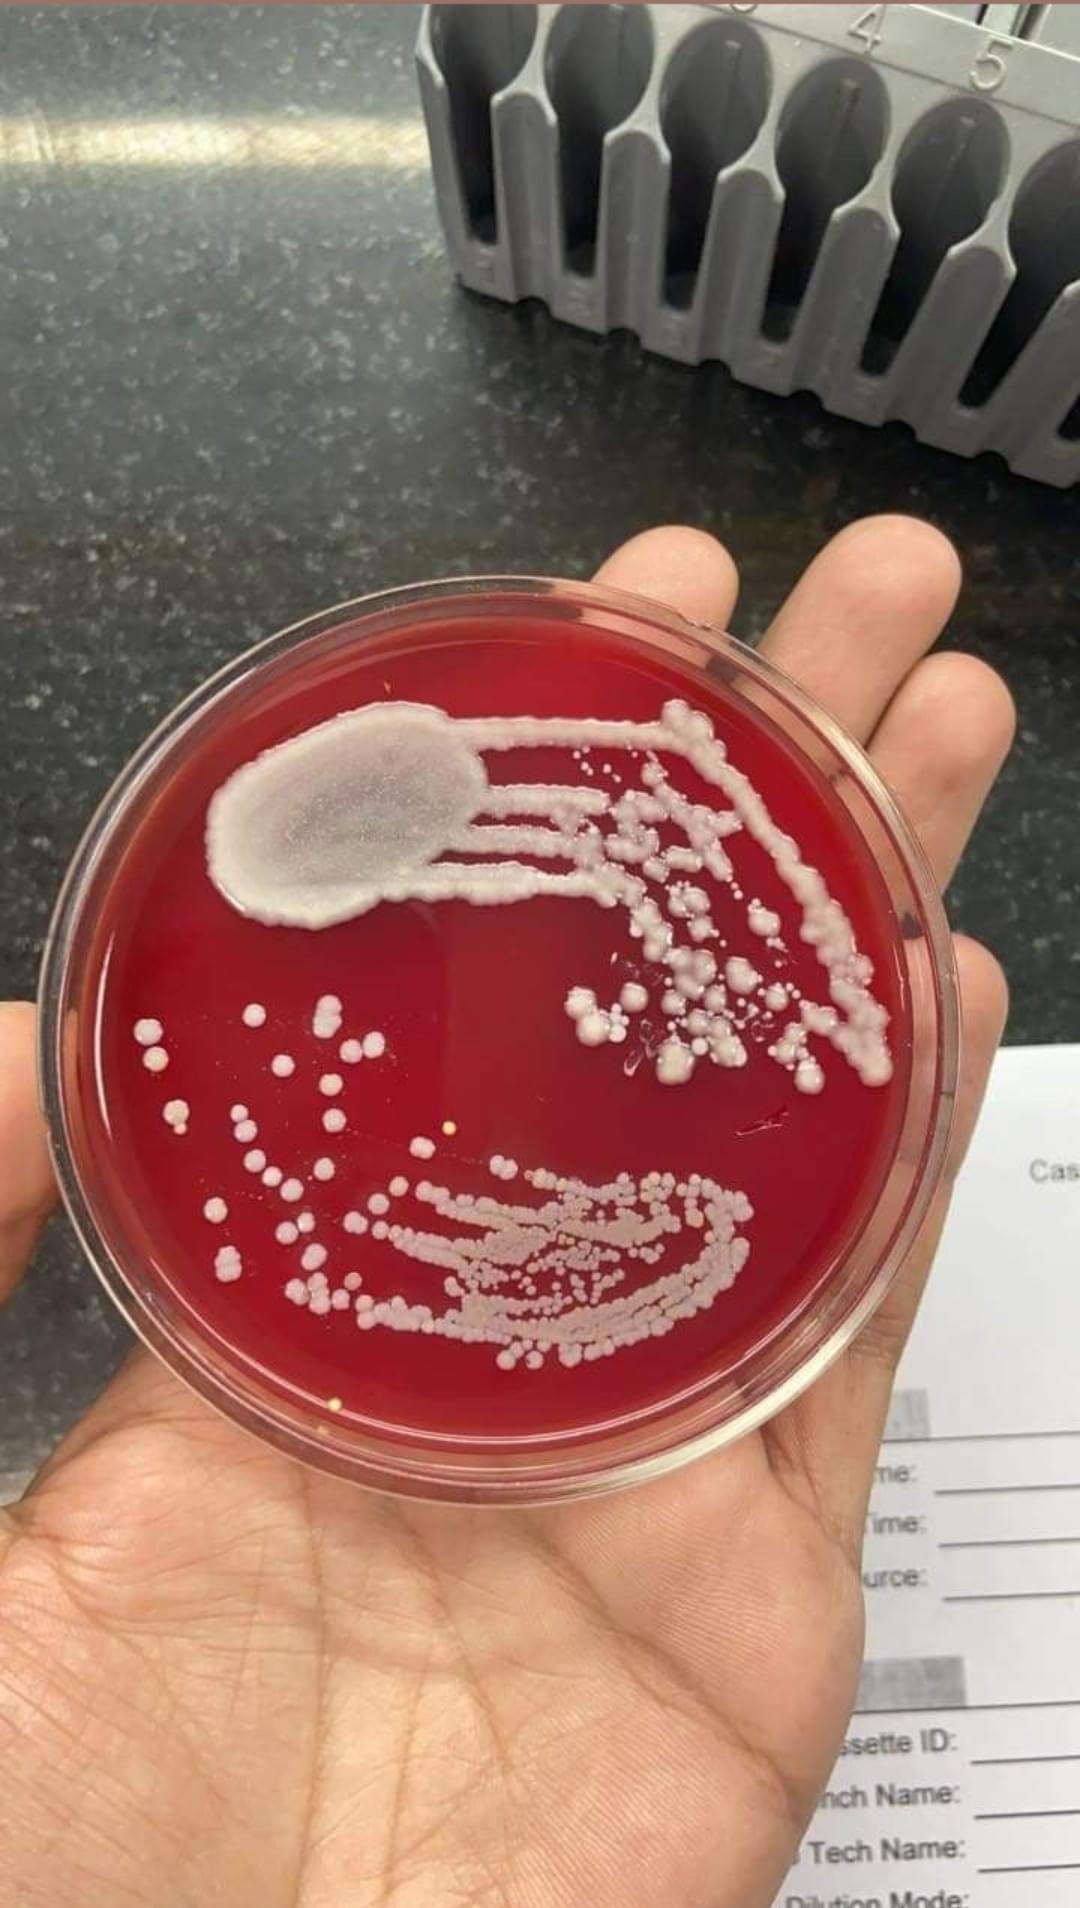

What Students Say
Likes
- Regarding boys to girls ratio in my department which is biotechnology, girls are more in number as compared to boys and regarding the CSE department the ratio is quite maintained though boys are more but girls are also not that few
- Comparing my college and course I am pursuing to other colleges I guess its quite worth it to study from here.
- I really like the campus life the lecture complexes and the environment inside the campus is happening and engaging.
Dislikes
- Hostel food is something which every student have issues with, it's not worse but yes it's not that great
- Waterlogging is a major issue as our campus is full of greenery during rainy season it becomes all muddy
- The in campus medical facilities is not good
Course Curriculum Overview
During my first year we had the same curriculum as CSE department just few subjects differ which was very good as we also got the opportunity to study programming languages. Though our new batch doesn't have this curriculum as per rule of the NEP.
Fees and Financial Aid
My complete college fees for the year 23-27 is 652000 after after applying girl scholarship of 40 percent which reduced it from 750000 to this much amount. Other scholarship are also available according to your percentage in class 12th and also the fees is increasing every year which I don't have much knowledge about
Campus Life
Campus life is fun, very engaging full of many events and pujas. We have 2 annual fests one is cultural and other is technical. Apart from that ganesh puja, janmashtami and navratri, dandiya night is also organised.
Hostel Facilities
Hostels are either triple sharing or single sharing in the form of a 3bhk flat. I have stayed in a triple seater during my first year and in single seater in my second year. Both differ in charges and you can choose accordingly personally I am a person who likes to interact with people but also after sometime I want my personal space so I feel so gle sharing is much better you get privacy there
Admission
I had many options but I chose this one because honestly biotech has lesser scope in india so I want to go abroad for higher studies so rather than paying a huge amount for a four yr degree I wanted to save up for my master's. Plus I don't the curriculum differs anyway
Faculty
The faculties are pretty good. They are polite sweet in nature. Regarding their teaching they are very dedicated towards it unlike any other colleges they focus on each and every student. I guess most of our faculties know each student by their name.
Night Life
Nightlife is safe, peaceful and happening. We enjoy long walks around the campus. We can order food till 10 only. We have in campus stores from which we can buy groceries and food stuff. We have 3 cafes inside our campus though they have their own timings.

![KIET Group of Institutions - [KIET]](https://image-static.collegedunia.com/public/college_data/images/logos/1741332786kietgroup.png?h=72&w=72&mode=stretch)
![KCC Institute of Technology and Management - [KCCITM]](https://image-static.collegedunia.com/public/college_data/images/logos/1679552824th.jpg?h=72&w=72&mode=stretch)

![GNIOT Group of Institutions - [GNIOT]](https://image-static.collegedunia.com/public/college_data/images/logos/1670413525index.png?h=72&w=72&mode=stretch)
![JSS Academy of Technical Education - [JSSATE]](https://image-static.collegedunia.com/public/college_data/images/logos/1600838773Logo.png?h=72&w=72&mode=stretch)
![Noida Institute of Engineering and Technology - [NIET]](https://image-static.collegedunia.com/public/college_data/images/logos/1741350549images2.png?h=72&w=72&mode=stretch)
![IILM Graduate School of Management - [IILM GSM]](https://image-static.collegedunia.com/public/college_data/images/logos/1763641741LOGOGOGOGO.webp?h=72&w=72&mode=stretch)
![Galgotias College of Engineering and Technology - [GCET]](https://image-static.collegedunia.com/public/college_data/images/logos/14769397071.jpg?h=72&w=72&mode=stretch)

Comments